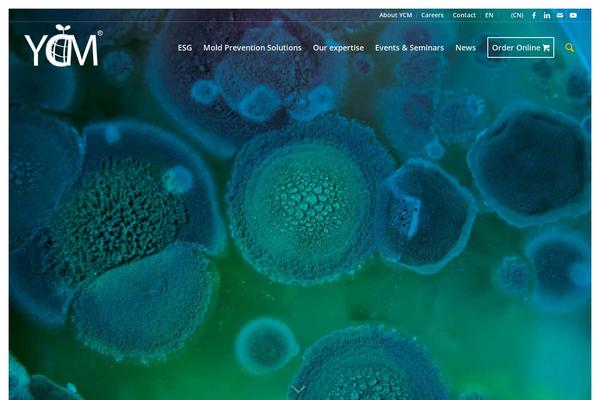
Site using Ultimate Member plugin

Recent update chart Ultimate Member by active site count on Themetix (April, 2024)
The change in the number of websites in the last monthly update +20 websites
-
From June to July website amount increased by
56 sites: 4.00%
From July to August website amount increased by 0 sites: 0.00 %
From August to September website amount increased by 194 sites: 13.32 %
From September to October website amount increased by 73 sites: 4.42 %
From October to November website amount increased by 117 sites: 6.79 %
From November to December website amount increased by 256 sites: 13.91 %
From December to January 2024 website amount increased by 192 sites: 9.16 %
From January to February 2024 website amount increased by 88 sites: 3.85 %
From February to March 2024 website amount increased by 153 sites: 6.44 %
From March to April 2024 website amount increased by 169 sites: 7.11 %
From April to May 2024 website amount increased by 78 sites: 3.08 %
How was changed amount of active sites built with Ultimate Member plugin for the research period (May, 2023 - April, 2024):